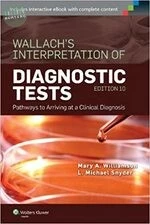
Wallach's Interpretation of Diagnostic Tests: Pathways to Arriving at a Clinical Diagnosis (10版)

【簡介】 Wallace the whale loves to sing! But with his asthma, will he be able to fulfil his dreams of winning the Meadowtown singing competition? Come join Wallace in his journey as he learns how to cope with his asthma The Baby Bear Paediatric Care Series features stories of compassion, focusing on pressing conditions and illnesses facing children in today''s world. Through engaging storytelling and beautiful illustrations, children, parents and educators will learn about various childhood conditions, and how they are addressed by doctors and hospitals. The series aims to spark discussion, and to build awareness and hope in children and adults. ABOUT THE AUTHORS Dr Leon Tan Yuan Rul is a paediatric resident based in KK Women''s and Children''s Hospital. Passionate in helping his young patients, he hopes to be able to play a part in motivating children in their asthma journeys. Dr Ting Chun Yi is an Associate Consultant with the Respiratory Medicine Service at KK Women''s and Children''s Hospital. She is passionate in her care of children with asthma and works with them and their families, supporting them towards achieving better asthma control. 【目錄】
還沒有人留下心得,快來搶頭香!
 資訊
資訊
 工程
工程
 數學與統計學
數學與統計學
 機率與統計
機率與統計
 自然科學
自然科學
 健康科學
健康科學
 地球與環境
地球與環境
 建築、設計與藝術
建築、設計與藝術
 人文與社會科學
人文與社會科學
 教育
教育
 語言學習與考試
語言學習與考試
 法律
法律
 會計與財務
會計與財務
 大眾傳播
大眾傳播
 觀光與休閒餐旅
觀光與休閒餐旅
 考試用書
考試用書
 研究方法
研究方法
 商業與管理
商業與管理
 經濟學
經濟學
 心理學
心理學
 生活
生活
 生活風格商品
生活風格商品
 參考書/測驗卷/輔材
參考書/測驗卷/輔材